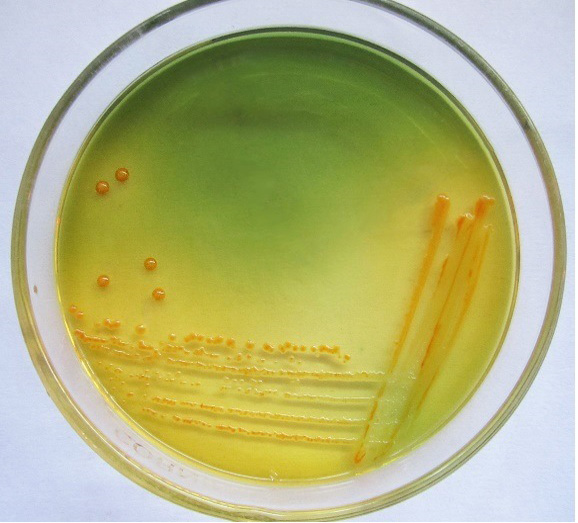
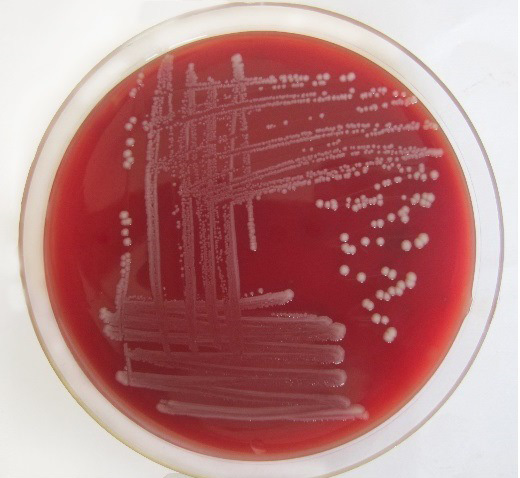
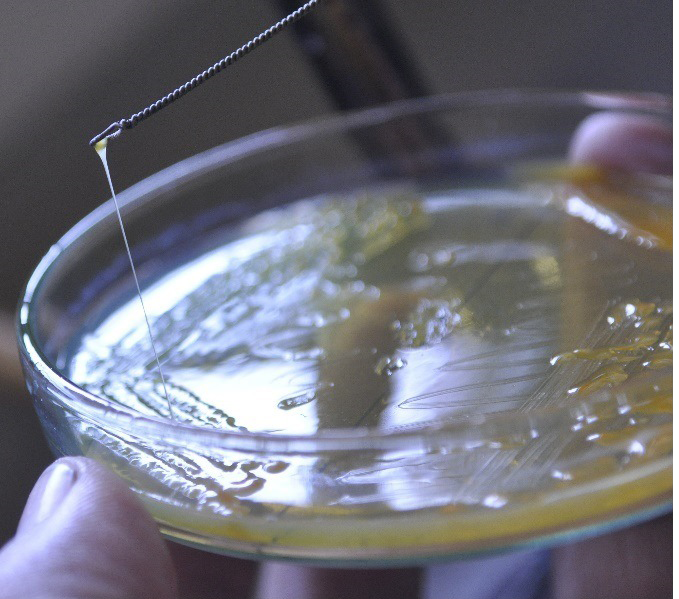

Advances in Animal and Veterinary Sciences
Research Article
Adv. Anim. Vet. Sci. 3 (2): 116 - 122
Figure 1
Klebsiella pneumoniae showing Yellow, dome shaped mucoid colonies on SCAI
Figure 2
Klebsiella pneumonaie isolates showing typical 130bp size product with specific primers on 8% polyacrylamide gel
Figure 3
Klebsiella pneumoniae showing non-hemolytic grey-white, mucoid colonies on sheep blood agar
Figure 4
Klebsiella pneumoniae showing virulent hypermucoviscosity trait (string test)